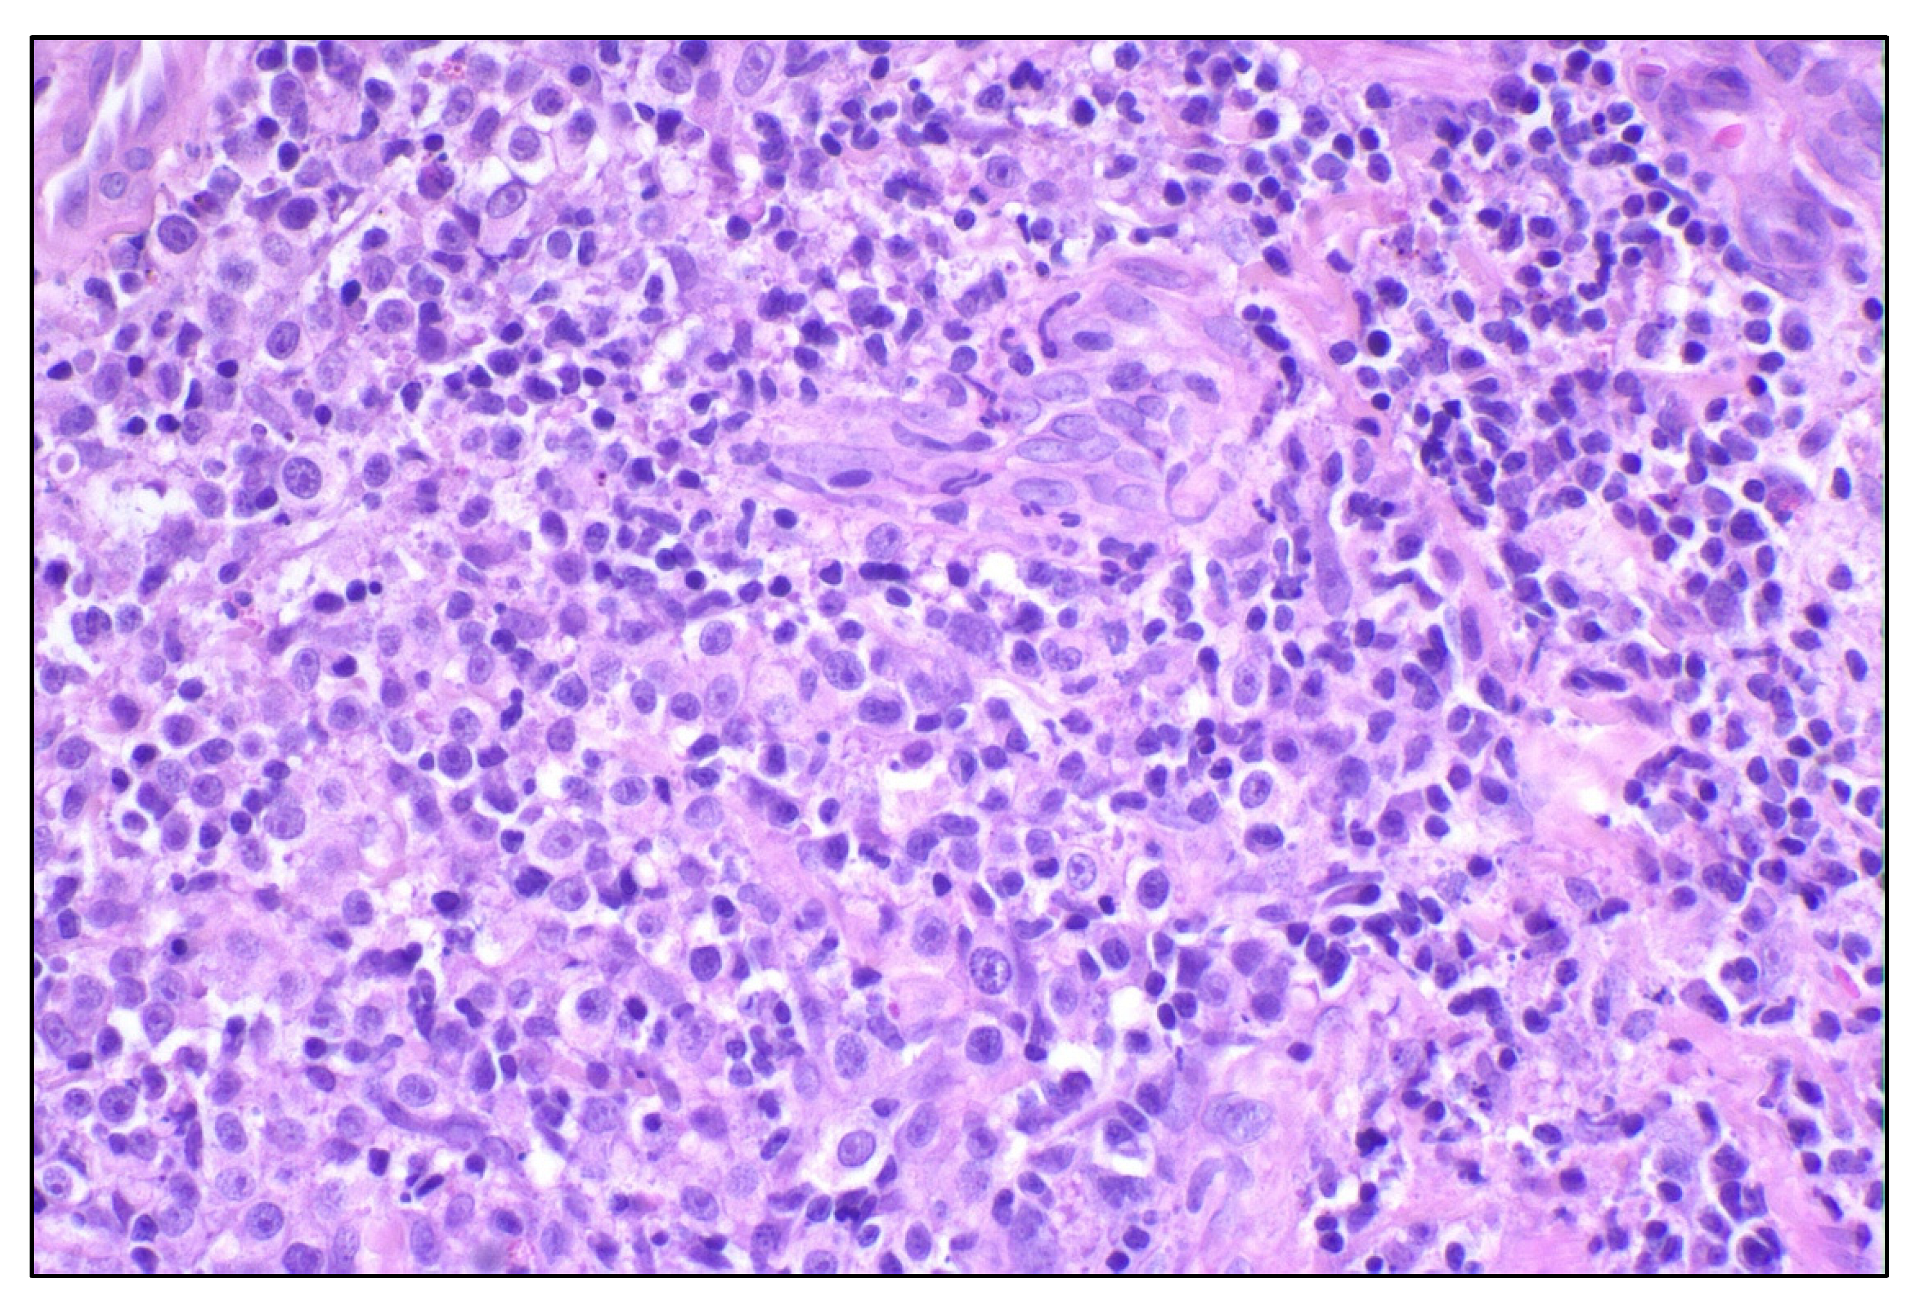
Cancers 14 05008 g002 Cancers 14 05008 g002

Comparative Evaluation of Tumor-Infiltrating Lymphocytes in Companion Animals: Immuno-Oncology as a Relevant Translational Model for Cancer Therapy
Abstract
Simple Summary
Abstract
1. Introduction
2. Veterinary Oncology as a Comparative Model
3. Tumor-Infiltrating Lymphocytes
3.1. TILs in Human Oncology
3.2. TILs in Veterinary Oncology
3.2.1. Transmissible Venereal Tumor (TVT)
3.2.2. Canine and Feline Mammary Carcinoma
3.2.3. Canine Oral Malignant Melanoma (OMM)
3.2.4. Canine Osteosarcoma (OSA)
3.2.5. Canine Histiocytic Neoplasms
3.2.6. Canine Gliomas
3.2.7. Canine Urothelial and Prostate Cancer
3.2.8. Canine Pulmonary Carcinoma
4. Comparative TIL Assessment and Future Directions
5. Conclusions
Author Contributions
Funding
Institutional Review Board Statement
Informed Consent Statement
Acknowledgments
Conflicts of Interest
References
- Schiffman, J.D.; Breen, M. Comparative Oncology: What Dogs and Other Species Can Teach Us about Humans with Cancer. Philos. Trans. R. Soc. B Biol. Sci. 2015, 370, 20140231. [Google Scholar] [CrossRef] [PubMed]
- Naghavi, M.; Abajobir, A.A.; Abbafati, C.; Abbas, K.M.; Abd-Allah, F.; Abera, S.F.; Aboyans, V.; Adetokunboh, O.; Afshin, A.; Agrawal, A.; et al. Global, Regional, and National Age-Sex Specific Mortality for 264 Causes of Death, 1980–2016: A Systematic Analysis for the Global Burden of Disease Study 2016. Lancet 2017, 390, 1151–1210. [Google Scholar] [CrossRef]
- Tabassum, D.P.; Polyak, K. Tumorigenesis: It Takes a Village. Nat. Rev. Cancer 2015, 15, 473–483. [Google Scholar] [CrossRef]
- Bleijs, M.; van de Wetering, M.; Clevers, H.; Drost, J. Xenograft and Organoid Model Systems in Cancer Research. EMBO J. 2019, 38, e101654. [Google Scholar] [CrossRef] [PubMed]
- Somarelli, J.A.; Boddy, A.M.; Gardner, H.L.; DeWitt, S.B.; Tuohy, J.; Megquier, K.; Sheth, M.U.; Hsu, S.D.; Thorne, J.L.; London, C.A.; et al. Improving Cancer Drug Discovery by Studying Cancer across the Tree of Life. Mol. Biol. Evol. 2019, 37, 11–17. [Google Scholar] [CrossRef] [PubMed]
- Verduin, M.; Hoeben, A.; Ruysscher, D.D.; Vooijs, M. Patient-Derived Cancer Organoids as Predictors of Treatment Response. Front. Oncol. 2021, 11, 641980. [Google Scholar] [CrossRef] [PubMed]
- Simpson, T.R.; Li, F.; Montalvo-Ortiz, W.; Sepulveda, M.A.; Bergerhoff, K.; Arce, F.; Roddie, C.; Henry, J.Y.; Yagita, H.; Wolchok, J.D.; et al. Fc-Dependent Depletion of Tumor-Infiltrating Regulatory T Cells Co-Defines the Efficacy of Anti–CTLA-4 Therapy against Melanoma. J. Exp. Med. 2013, 210, 1695–1710. [Google Scholar] [CrossRef] [PubMed]
- Romano, E.; Kusio-Kobialka, M.; Foukas, P.G.; Baumgaertner, P.; Meyer, C.; Ballabeni, P.; Michielin, O.; Weide, B.; Romero, P.; Speiser, D.E. Ipilimumab-Dependent Cell-Mediated Cytotoxicity of Regulatory T Cells Ex Vivo by Nonclassical Monocytes in Melanoma Patients. Proc. Natl. Acad. Sci. USA 2015, 112, 6140–6145. [Google Scholar] [CrossRef]
- Robert, C.; Thomas, L.; Bondarenko, I.; O’Day, S.; Weber, J.; Garbe, C.; Lebbe, C.; Baurain, J.-F.; Testori, A.; Grob, J.-J.; et al. Ipilimumab plus Dacarbazine for Previously Untreated Metastatic Melanoma. N. Engl. J. Med. 2011, 364, 2517–2526. [Google Scholar] [CrossRef] [PubMed]
- Topalian, S.L.; Hodi, F.S.; Brahmer, J.R.; Gettinger, S.N.; Smith, D.C.; McDermott, D.F.; Powderly, J.D.; Carvajal, R.D.; Sosman, J.A.; Atkins, M.B.; et al. Safety, Activity, and Immune Correlates of Anti–PD-1 Antibody in Cancer. N. Engl. J. Med. 2012, 366, 2443–2454. [Google Scholar] [CrossRef]
- Nishio, M.; Barlesi, F.; West, H.; Ball, S.; Bordoni, R.; Cobo, M.; Longeras, P.D.; Goldschmidt, J.; Novello, S.; Orlandi, F.; et al. Atezolizumab Plus Chemotherapy for First-Line Treatment of Nonsquamous NSCLC: Results From the Randomized Phase 3 IMpower132 Trial. J. Thorac. Oncol. 2021, 16, 653–664. [Google Scholar] [CrossRef]
- Joseph, M.; Enting, D. Immune Responses in Bladder Cancer-Role of Immune Cell Populations, Prognostic Factors and Therapeutic Implications. Front. Oncol. 2019, 9, 1270. [Google Scholar] [CrossRef] [PubMed]
- West, H.; McCleod, M.; Hussein, M.; Morabito, A.; Rittmeyer, A.; Conter, H.J.; Kopp, H.-G.; Daniel, D.; McCune, S.; Mekhail, T.; et al. Atezolizumab in Combination with Carboplatin plus Nab-Paclitaxel Chemotherapy Compared with Chemotherapy Alone as First-Line Treatment for Metastatic Non-Squamous Non-Small-Cell Lung Cancer (IMpower130): A Multicentre, Randomised, Open-Label, Phase 3 Trial. Lancet Oncol. 2019, 20, 924–937. [Google Scholar] [CrossRef]
- Galsky, M.D.; Arija, J.Á.A.; Bamias, A.; Davis, I.D.; Santis, M.D.; Kikuchi, E.; Garcia-del-Muro, X.; Giorgi, U.D.; Mencinger, M.; Izumi, K.; et al. Atezolizumab with or without Chemotherapy in Metastatic Urothelial Cancer (IMvigor130): A Multicentre, Randomised, Placebo-Controlled Phase 3 Trial. Lancet 2020, 395, 1547–1557. [Google Scholar] [CrossRef]
- Denkert, C.; von Minckwitz, G.; Darb-Esfahani, S.; Lederer, B.; Heppner, B.I.; Weber, K.E.; Budczies, J.; Huober, J.; Klauschen, F.; Furlanetto, J.; et al. Tumour-Infiltrating Lymphocytes and Prognosis in Different Subtypes of Breast Cancer: A Pooled Analysis of 3771 Patients Treated with Neoadjuvant Therapy. Lancet Oncol. 2018, 19, 40–50. [Google Scholar] [CrossRef]
- Salgado, R.; Denkert, C.; Demaria, S.; Sirtaine, N.; Klauschen, F.; Pruneri, G.; Wienert, S.; van den Eynden, G.; Baehner, F.L.; Penault-Llorca, F.; et al. The Evaluation of Tumor-Infiltrating Lymphocytes (TILs) in Breast Cancer: Recommendations by an International TILs Working Group 2014. Ann. Oncol. 2015, 26, 259–271. [Google Scholar] [CrossRef] [PubMed]
- Quail, D.F.; Joyce, J.A. Microenvironmental Regulation of Tumor Progression and Metastasis. Nat. Med. 2013, 19, 1423–1437. [Google Scholar] [CrossRef] [PubMed]
- Rowell, J.L.; McCarthy, D.O.; Alvarez, C.E. Dog Models of Naturally Occurring Cancer. Trends Mol. Med. 2011, 17, 380–388. [Google Scholar] [CrossRef]
- Baioni, E.; Scanziani, E.; Vincenti, M.C.; Leschiera, M.; Bozzetta, E.; Pezzolato, M.; Desiato, R.; Bertolini, S.; Maurella, C.; Ru, G. Estimating Canine Cancer Incidence: Findings from a Population-Based Tumour Registry in Northwestern Italy. BMC Vet. Res. 2017, 13, 203. [Google Scholar] [CrossRef] [PubMed]
- Dobson, J.M.; Samuel, S.; Milstein, H.; Rogers, K.; Wood, J.L.N. Canine Neoplasia in the UK: Estimates of Incidence Rates from a Population of Insured Dogs. J. Small Anim. Pract. 2002, 43, 240–246. [Google Scholar] [CrossRef] [PubMed]
- Merlo, D.F.; Rossi, L.; Pellegrino, C.; Ceppi, M.; Cardellino, U.; Capurro, C.; Ratto, A.; Sambucco, P.L.; Sestito, V.; Tanara, G.; et al. Cancer Incidence in Pet Dogs: Findings of the Animal Tumor Registry of Genoa, Italy. J. Vet. Intern. Med. 2008, 22, 976–984. [Google Scholar] [CrossRef]
- Vascellari, M.; Baioni, E.; Ru, G.; Carminato, A.; Mutinelli, F. Animal Tumour Registry of Two Provinces in Northern Italy: Incidence of Spontaneous Tumours in Dogs and Cats. BMC Vet. Res. 2009, 5, 39. [Google Scholar] [CrossRef]
- Graf, R.; Pospischil, A.; Guscetti, F.; Meier, D.; Welle, M.; Dettwiler, M. Cutaneous Tumors in Swiss Dogs: Retrospective Data From the Swiss Canine Cancer Registry, 2008–2013. Vet. Pathol. 2018, 55, 809–820. [Google Scholar] [CrossRef] [PubMed]
- LeBlanc, A.K.; Mazcko, C.N. Improving Human Cancer Therapy through the Evaluation of Pet Dogs. Nat. Rev. Cancer 2020, 20, 727–742. [Google Scholar] [CrossRef] [PubMed]
- Paoloni, M.; Khanna, C. Translation of New Cancer Treatments from Pet Dogs to Humans. Nat. Rev. Cancer 2008, 8, 147–156. [Google Scholar] [CrossRef] [PubMed]
- Tawa, G.J.; Braisted, J.; Gerhold, D.; Grewal, G.; Mazcko, C.; Breen, M.; Sittampalam, G.; LeBlanc, A.K. Transcriptomic Profiling in Canines and Humans Reveals Cancer Specific Gene Modules and Biological Mechanisms Common to Both Species. PLoS Comput. Biol. 2021, 17, e1009450. [Google Scholar] [CrossRef] [PubMed]
- LeBlanc, A.K.; Breen, M.; Choyke, P.; Dewhirst, M.; Fan, T.M.; Gustafson, D.L.; Helman, L.J.; Kastan, M.B.; Knapp, D.W.; Levin, W.J.; et al. Perspectives from Man’s Best Friend: National Academy of Medicine’s Workshop on Comparative Oncology. Sci. Transl. Med. 2016, 8, ps5–ps324. [Google Scholar] [CrossRef] [PubMed]
- Stroud, C.; Dmitriev, I.; Kashentseva, E.; Bryan, J.N.; Curiel, D.T.; Rindt, H.; Reinero, C.; Henry, C.J.; Bergman, P.J.; Mason, N.J.; et al. A One Health Overview, Facilitating Advances in Comparative Medicine and Translational Research. Clin. Transl. Med. 2016, 5, 26. [Google Scholar] [CrossRef]
- Amin, S.B.; Anderson, K.J.; Boudreau, C.E.; Martinez-Ledesma, E.; Kocakavuk, E.; Johnson, K.C.; Barthel, F.P.; Varn, F.S.; Kassab, C.; Ling, X.; et al. Comparative Molecular Life History of Spontaneous Canine and Human Gliomas. Cancer Cell 2020, 37, 243–257.e7. [Google Scholar] [CrossRef]
- Barutello, G.; Rolih, V.; Arigoni, M.; Tarone, L.; Conti, L.; Quaglino, E.; Buracco, P.; Cavallo, F.; Riccardo, F. Strengths and Weaknesses of Pre-Clinical Models for Human Melanoma Treatment: Dawn of Dogs’ Revolution for Immunotherapy. Int. J. Mol. Sci. 2018, 19, 799. [Google Scholar] [CrossRef]
- Sabichi, A.L.; Lee, J.J.; Grossman, H.B.; Liu, S.; Richmond, E.; Czerniak, B.A.; De la Cerda, J.; Eagle, C.; Viner, J.L.; Palmer, J.L.; et al. A Randomized Controlled Trial of Celecoxib to Prevent Recurrence of Nonmuscle-Invasive Bladder Cancer. Cancer Prev. Res. 2011, 4, 1580–1589. [Google Scholar] [CrossRef] [PubMed]
- Dhawan, D.; Craig, B.A.; Cheng, L.; Snyder, P.W.; Mohammed, S.I.; Stewart, J.C.; Zheng, R.; Loman, R.A.; Foster, R.S.; Knapp, D.W. Effects of Short-Term Celecoxib Treatment in Patients with Invasive Transitional Cell Carcinoma of the Urinary Bladder. Mol. Cancer Ther. 2010, 9, 1371–1377. [Google Scholar] [CrossRef] [PubMed]
- Fulkerson, C.M.; Dhawan, D.; Ratliff, T.L.; Hahn, N.M.; Knapp, D.W. Naturally Occurring Canine Invasive Urinary Bladder Cancer: A Complementary Animal Model to Improve the Success Rate in Human Clinical Trials of New Cancer Drugs. Int. J. Genom. 2017, 2017, 6589529. [Google Scholar] [CrossRef]
- Dhawan, D.; Hahn, N.M.; Ramos-Vara, J.A.; Knapp, D.W. Naturally-Occurring Canine Invasive Urothelial Carcinoma Harbors Luminal and Basal Transcriptional Subtypes Found in Human Muscle Invasive Bladder Cancer. PLoS Genet. 2018, 14, e1007571. [Google Scholar] [CrossRef]
- Knapp, D.W.; Glickman, N.W.; DeNicola, D.B.; Bonney, P.L.; Lin, T.L.; Glickman, L.T. Naturally-Occurring Canine Transitional Cell Carcinoma of the Urinary Bladder A Relevant Model of Human Invasive Bladder Cancer. Urol. Oncol. Semin. Orig. Investig. 2000, 5, 47–59. [Google Scholar] [CrossRef]
- Knapp, D.W.; Dhawan, D.; Ramos-Vara, J.A.; Ratliff, T.L.; Cresswell, G.M.; Utturkar, S.; Sommer, B.C.; Fulkerson, C.M.; Hahn, N.M. Naturally-Occurring Invasive Urothelial Carcinoma in Dogs, a Unique Model to Drive Advances in Managing Muscle Invasive Bladder Cancer in Humans. Front. Oncol. 2020, 9, 1493. [Google Scholar] [CrossRef]
- Pinard, C.J.; Stegelmeier, A.A.; Bridle, B.W.; Mutsaers, A.J.; Wood, D.; Wood, G.A.; Woods, J.P.; Hocker, S.E. Evaluation of Lymphocyte-specific PD-1 Receptor Expression and Cytokines in Blood and Urine in Canine Urothelial Carcinoma Patients. Vet. Comp. Oncol. 2021, 20, 427–436. [Google Scholar] [CrossRef]
- Cronise, K.E.; Das, S.; Hernandez, B.G.; Regan, D.P.; Dailey, D.D.; McGeachan, R.I.; Lana, S.E.; Page, R.L.; Gustafson, D.L.; Duval, D.L. Characterizing the Molecular and Immune Landscape of Canine Bladder Cancer. Vet. Comp. Oncol. 2021. [CrossRef]
- Mizuno, T.; Kato, Y.; Kaneko, M.K.; Sakai, Y.; Shiga, T.; Kato, M.; Tsukui, T.; Takemoto, H.; Tokimasa, A.; Baba, K.; et al. Generation of a Canine Anti-Canine CD20 Antibody for Canine Lymphoma Treatment. Sci. Rep. 2020, 10, 11476. [Google Scholar] [CrossRef]
- Ito, D.; Brewer, S.; Modiano, J.F.; Beall, M.J. Development of a Novel Anti-Canine CD20 Monoclonal Antibody with Diagnostic and Therapeutic Potential. Leuk. Lymphoma 2014, 56, 219–225. [Google Scholar] [CrossRef]
- Fenger, J.M.; London, C.A.; Kisseberth, W.C. Canine Osteosarcoma: A Naturally Occurring Disease to Inform Pediatric Oncology. ILAR J. 2014, 55, 69–85. [Google Scholar] [CrossRef] [PubMed]
- Poon, A.C.; Matsuyama, A.; Mutsaers, A.J. Recent and Current Clinical Trials in Canine Appendicular Osteosarcoma. Can. Vet. J. 2020, 61, 301–308. [Google Scholar] [PubMed]
- Mason, N.J.; Gnanandarajah, J.S.; Engiles, J.B.; Gray, F.; Laughlin, D.; Gaurnier-Hausser, A.; Wallecha, A.; Huebner, M.; Paterson, Y. Immunotherapy with a HER2-Targeting Listeria Induces HER2-Specific Immunity and Demonstrates Potential Therapeutic Effects in a Phase I Trial in Canine Osteosarcoma. Clin. Cancer Res. 2016, 22, 4380–4390. [Google Scholar] [CrossRef]
- Rebhun, R.B.; York, D.; Cruz, S.M.; Judge, S.J.; Razmara, A.M.; Farley, L.E.; Brady, R.V.; Johnson, E.G.; Burton, J.H.; Willcox, J.; et al. Inhaled Recombinant Human IL-15 in Dogs with Naturally Occurring Pulmonary Metastases from Osteosarcoma or Melanoma: A Phase 1 Study of Clinical Activity and Correlates of Response. J. Immunother. Cancer 2022, 10, e004493. [Google Scholar] [CrossRef] [PubMed]
- Somarelli, J.A.; Rupprecht, G.; Altunel, E.; Flamant, E.M.; Rao, S.; Sivaraj, D.; Lazarides, A.L.; Hoskinson, S.M.; Sheth, M.U.; Cheng, S.; et al. A Comparative Oncology Drug Discovery Pipeline to Identify and Validate New Treatments for Osteosarcoma. Cancers 2020, 12, 3335. [Google Scholar] [CrossRef]
- LeBlanc, A.K.; Mazcko, C.N.; Khanna, C. Defining the Value of a Comparative Approach to Cancer Drug Development. Am. Assoc. Cancer Res. 2016, 22, 2133–2138. [Google Scholar] [CrossRef]
- Burton, J.H.; Mazcko, C.N.; LeBlanc, A.K.; Covey, J.M.; Ji, J.; Kinders, R.J.; Parchment, R.E.; Khanna, C.; Paoloni, M.; Lana, S.E.; et al. NCI Comparative Oncology Program Testing of Non-Camptothecin Indenoisoquinoline Topoisomerase I Inhibitors in Naturally Occurring Canine Lymphoma. Clin. Cancer Res. 2018, 24, 5830–5840. [Google Scholar] [CrossRef]
- Gordon, I.; Paoloni, M.; Mazcko, C.; Khanna, C. The Comparative Oncology Trials Consortium: Using Spontaneously Occurring Cancers in Dogs to Inform the Cancer Drug Development Pathway. PLoS Med. 2009, 6, e1000161. [Google Scholar] [CrossRef]
- LeBlanc, A.K. Cancer and Comparative Imaging. ILAR J. 2014, 55, 164–168. [Google Scholar] [CrossRef]
- Vail, D.M.; LeBlanc, A.K.; Jeraj, R. Advanced Cancer Imaging Applied in the Comparative Setting. Front. Oncol. 2020, 10, 84. [Google Scholar] [CrossRef]
- Tamburini, B.A.; Trapp, S.; Phang, T.L.; Schappa, J.T.; Hunter, L.E.; Modiano, J.F. Gene Expression Profiles of Sporadic Canine Hemangiosarcoma Are Uniquely Associated with Breed. PLoS ONE 2009, 4, e5549. [Google Scholar] [CrossRef] [PubMed]
- Overgaard, N.H.; Fan, T.M.; Schachtschneider, K.M.; Principe, D.R.; Schook, L.B.; Jungersen, G. Of Mice, Dogs, Pigs, and Men: Choosing the Appropriate Model for Immuno-Oncology Research. ILAR J. 2018, 59, 247–262. [Google Scholar] [CrossRef] [PubMed]
- Moore, P.F.; Rossitto, P.V.; Danilenko, D.M.; Wielenga, J.J.; Raff, R.F.; Severns, E. Monoclonal Antibodies Specific for Canine CD4 and CD8 Define Functional T-lymphocyte Subsets and High-density Expression of CD4 by Canine Neutrophils. Tissue Antigens 1992, 40, 75–85. [Google Scholar] [CrossRef]
- Park, J.S.; Withers, S.S.; Modiano, J.F.; Kent, M.S.; Chen, M.; Luna, J.I.; Culp, W.T.N.; Sparger, E.E.; Rebhun, R.B.; Monjazeb, A.M.; et al. Canine Cancer Immunotherapy Studies: Linking Mouse and Human. J. Immunother. Cancer 2016, 4, 97. [Google Scholar] [CrossRef]
- Dow, S. A Role for Dogs in Advancing Cancer Immunotherapy Research. Front. Immunol. 2020, 10, 2935. [Google Scholar] [CrossRef]
- Goulart, M.R.; Hlavaty, S.I.; Chang, Y.-M.; Polton, G.; Stell, A.; Perry, J.; Wu, Y.; Sharma, E.; Broxholme, J.; Lee, A.C.; et al. Phenotypic and Transcriptomic Characterization of Canine Myeloid-Derived Suppressor Cells. Sci. Rep. 2019, 9, 3574. [Google Scholar] [CrossRef]
- Gingrich, A.A.; Reiter, T.E.; Judge, S.J.; York, D.; Yanagisawa, M.; Razmara, A.; Sturgill, I.; Basmaci, U.N.; Brady, R.V.; Stoffel, K.; et al. Comparative Immunogenomics of Canine Natural Killer Cells as Immunotherapy Target. Front. Immunol. 2021, 12, 670309. [Google Scholar] [CrossRef]
- Shin, I.-S.; Choi, E.-W.; Chung, J.-Y.; Hwang, C.-Y.; Lee, C.-W.; Youn, H.-Y. Cloning, Expression and Bioassay of Canine CTLA4Ig. Vet. Immunol. Immunopathol. 2007, 118, 12–18. [Google Scholar] [CrossRef]
- Maekawa, N.; Konnai, S.; Ikebuchi, R.; Okagawa, T.; Adachi, M.; Takagi, S.; Kagawa, Y.; Nakajima, C.; Suzuki, Y.; Murata, S.; et al. Expression of PD-L1 on Canine Tumor Cells and Enhancement of IFN-γ Production from Tumor-Infiltrating Cells by PD-L1 Blockade. PLoS ONE 2014, 9, e98415. [Google Scholar] [CrossRef] [PubMed]
- Shosu, K.; Sakurai, M.; Inoue, K.; Nakagawa, T.; Sakai, H.; Morimoto, M.; Okuda, M.; Noguchi, S.; Mizuno, T. Programmed Cell Death Ligand 1 Expression in Canine Cancer. In Vivo 2016, 30, 195–204. [Google Scholar]
- Tagawa, M.; Maekawa, N.; Konnai, S.; Takagi, S. Evaluation of Costimulatory Molecules in Peripheral Blood Lymphocytes of Canine Patients with Histiocytic Sarcoma. PLoS ONE 2016, 11, e0150030. [Google Scholar] [CrossRef] [PubMed]
- Coy, J.; Caldwell, A.; Chow, L.; Guth, A.; Dow, S. PD-1 Expression by Canine T Cells and Functional Effects of PD-1 Blockade. Vet. Comp. Oncol. 2017, 15, 1487–1502. [Google Scholar] [CrossRef] [PubMed]
- Nascimento, C.; Urbano, A.C.; Gameiro, A.; Ferreira, J.; Correia, J.; Ferreira, F. Serum PD-1/PD-L1 Levels, Tumor Expression and PD-L1 Somatic Mutations in HER2-Positive and Triple Negative Normal-Like Feline Mammary Carcinoma Subtypes. Cancers 2020, 12, 1386. [Google Scholar] [CrossRef] [PubMed]
- Costa, V.R.; Soileau, A.M.; Liu, C.-C.; Moeller, C.E.; Carossino, M.; Langohr, I.M.; Withers, S.S. Exploring the Association of Intratumoral Immune Cell Infiltrates with Histopathologic Grade in Canine Mast Cell Tumors. Res. Vet. Sci. 2022, 147, 83–91. [Google Scholar] [CrossRef] [PubMed]
- Mason, N.J.; Chester, N.; Xiong, A.; Rotolo, A.; Wu, Y.; Yoshimoto, S.; Glassman, P.; Gulendran, G.; Siegel, D.L. Development of a Fully Canine Anti-Canine CTLA4 Monoclonal Antibody for Comparative Translational Research in Dogs with Spontaneous Tumors. MAbs 2021, 13, 2004638. [Google Scholar] [CrossRef] [PubMed]
- Maekawa, N.; Konnai, S.; Nishimura, M.; Kagawa, Y.; Takagi, S.; Hosoya, K.; Ohta, H.; Kim, S.; Okagawa, T.; Izumi, Y.; et al. PD-L1 Immunohistochemistry for Canine Cancers and Clinical Benefit of Anti-PD-L1 Antibody in Dogs with Pulmonary Metastatic Oral Malignant Melanoma. NPJ Precis. Oncol. 2021, 5, 10. [Google Scholar] [CrossRef] [PubMed]
- Maekawa, N.; Konnai, S.; Takagi, S.; Kagawa, Y.; Okagawa, T.; Nishimori, A.; Ikebuchi, R.; Izumi, Y.; Deguchi, T.; Nakajima, C.; et al. A Canine Chimeric Monoclonal Antibody Targeting PD-L1 and Its Clinical Efficacy in Canine Oral Malignant Melanoma or Undifferentiated Sarcoma. Sci. Rep. 2017, 7, 8951. [Google Scholar] [CrossRef] [PubMed]
- Panjwani, M.K.; Smith, J.B.; Schutsky, K.; Gnanandarajah, J.; O’Connor, C.M.; Powell, D.J.; Mason, N.J. Feasibility and Safety of RNA-Transfected CD20-Specific Chimeric Antigen Receptor T Cells in Dogs with Spontaneous B Cell Lymphoma. Mol. Ther. 2016, 24, 1602–1614. [Google Scholar] [CrossRef] [PubMed]
- Dow, S.W.; Elmslie, R.E.; Willson, A.P.; Roche, L.; Gorman, C.; Potter, T.A. In Vivo Tumor Transfection with Superantigen plus Cytokine Genes Induces Tumor Regression and Prolongs Survival in Dogs with Malignant Melanoma. J. Clin. Investig. 1998, 101, 2406–2414. [Google Scholar] [CrossRef] [PubMed]
- U’Ren, L.W.; Biller, B.J.; Elmslie, R.E.; Thamm, D.H.; Dow, S.W. Evaluation of a Novel Tumor Vaccine in Dogs with Hemangiosarcoma. J. Vet. Intern. Med. 2007, 21, 113. [Google Scholar] [CrossRef]
- Manley, C.A.; Leibman, N.F.; Wolchok, J.D.; Rivière, I.C.; Bartido, S.; Craft, D.M.; Bergman, P.J. Xenogeneic Murine Tyrosinase DNA Vaccine for Malignant Melanoma of the Digit of Dogs. J. Vet. Intern. Med. 2011, 25, 94–99. [Google Scholar] [CrossRef] [PubMed]
- Kisseberth, W.C.; Lee, D.A. Adoptive Natural Killer Cell Immunotherapy for Canine Osteosarcoma. Front. Vet. Sci. 2021, 8, 672361. [Google Scholar] [CrossRef] [PubMed]
- Lucroy, M.D.; Clauson, R.M.; Suckow, M.A.; El-Tayyeb, F.; Kalinauskas, A. Evaluation of an Autologous Cancer. Vaccine for the Treatment of Metastatic Canine Hemangiosarcoma: A Preliminary Study. BMC Vet. Res. 2020, 16, 447. [Google Scholar] [CrossRef]
- Flesner, B.K.; Wood, G.W.; Gayheart-Walsten, P.; Sonderegger, F.L.; Henry, C.J.; Tate, D.J.; Bechtel, S.M.; Donnelly, L.L.; Johnson, G.C.; Kim, D.Y.; et al. Autologous Cancer. Cell Vaccination, Adoptive T-cell Transfer, and Interleukin-2 Administration Results in Long-term Survival for Companion Dogs with Osteosarcoma. J. Vet. Intern. Med. 2020, 34, 2056–2067. [Google Scholar] [CrossRef] [PubMed]
- Paoloni, M.; Mazcko, C.; Selting, K.; Lana, S.; Barber, L.; Phillips, J.; Skorupski, K.; Vail, D.; Wilson, H.; Biller, B.; et al. Defining the Pharmacodynamic Profile and Therapeutic Index of NHS-IL12 Immunocytokine in Dogs with Malignant Melanoma. PLoS ONE 2015, 10, e0129954. [Google Scholar] [CrossRef] [PubMed]
- Alonso-Miguel, D.; Valdivia, G.; Guerrera, D.; Perez-Alenza, M.D.; Pantelyushin, S.; Alonso-Diez, A.; Beiss, V.; Fiering, S.; Steinmetz, N.F.; Suarez-Redondo, M.; et al. Neoadjuvant In Situ Vaccination with Cowpea Mosaic Virus as a Novel Therapy against Canine Inflammatory Mammary Cancer. J. Immunother. Cancer 2022, 10, e004044. [Google Scholar] [CrossRef] [PubMed]
- Titov, A.; Kaminskiy, Y.; Ganeeva, I.; Zmievskaya, E.; Valiullina, A.; Rakhmatullina, A.; Petukhov, A.; Miftakhova, R.; Rizvanov, A.; Bulatov, E. Knowns and Unknowns about CAR-T Cell Dysfunction. Cancers 2022, 14, 1078. [Google Scholar] [CrossRef]
- Ramos-Cardona, X.E.; Luo, W.; Mohammed, S.I. Advances and Challenges of CAR T Therapy and Suitability of Animal Models (Review). Mol. Clin. Oncol. 2022, 17, 134. [Google Scholar] [CrossRef]
- Clark, W.H.; Elder, D.E.; Guerry, D.; Braitman, L.E.; Trock, B.J.; Schultz, D.; Synnestvedt, M.; Halpern, A.C. Model Predicting Survival in Stage I Melanoma Based on Tumor Progression. J. Natl. Cancer Inst. 1989, 81, 1893–1904. [Google Scholar] [CrossRef]
- Clemente, C.G.; Mihm, M.C.; Bufalino, R.; Zurrida, S.; Collini, P.; Cascinelli, N. Prognostic Value of Tumor Infiltrating Lymphocytes in the Vertical Growth Phase of Primary Cutaneous Melanoma. Cancer 1996, 77, 1303–1310. [Google Scholar] [CrossRef]
- Carvalho, M.I.; Pires, I.; Prada, J.; Queiroga, F.L. A Role for T-Lymphocytes in Human Breast Cancer and in Canine Mammary Tumors. Biomed Res. Int. 2014, 2014, 130894. [Google Scholar] [CrossRef] [PubMed]
- Liu, Y.-T.; Sun, Z.-J. Turning Cold Tumors into Hot Tumors by Improving T-Cell Infiltration. Theranostics 2021, 11, 5365–5386. [Google Scholar] [CrossRef]
- Paijens, S.T.; Vledder, A.; de Bruyn, M.; Nijman, H.W. Tumor-Infiltrating Lymphocytes in the Immunotherapy Era. Cell. Mol. Immunol. 2021, 18, 842–859. [Google Scholar] [CrossRef]
- Oner, G.; Altintas, S.; Canturk, Z.; Tjalma, W.; Verhoeven, Y.; Berckelaer, C.V.; Berneman, Z.; Peeters, M.; Pauwels, P.; Dam, P.A. Triple-negative Breast Cancer.—Role of Immunology: A Systemic Review. Breast J. 2020, 26, 995–999. [Google Scholar] [CrossRef] [PubMed]
- Nuciforo, P.; Pascual, T.; Cortés, J.; Llombart-Cussac, A.; Fasani, R.; Paré, L.; Oliveira, M.; Galvan, P.; Martínez, N.; Bermejo, B.; et al. A Predictive Model of Pathologic Response Based on Tumor Cellularity and Tumor-Infiltrating Lymphocytes (CelTIL) in HER2-Positive Breast Cancer Treated with Chemo-Free Dual HER2 Blockade. Ann. Oncol. 2018, 29, 170–177. [Google Scholar] [CrossRef]
- Ochi, T.; Bianchini, G.; Ando, M.; Nozaki, F.; Kobayashi, D.; Criscitiello, C.; Curigliano, G.; Iwamoto, T.; Niikura, N.; Takei, H.; et al. Predictive and Prognostic Value of Stromal Tumour-Infiltrating Lymphocytes before and after Neoadjuvant Therapy in Triple Negative and HER2-Positive Breast Cancer. Eur. J. Cancer 2019, 118, 41–48. [Google Scholar] [CrossRef]
- Khoury, T.; Nagrale, V.; Opyrchal, M.; Peng, X.; Wang, D.; Yao, S. Prognostic Significance of Stromal versus Intratumoral Infiltrating Lymphocytes in Different Subtypes of Breast Cancer. Treated with Cytotoxic Neoadjuvant Chemotherapy. Appl. Immunohistochem. Mol. Morphol. 2018, 26, 523–532. [Google Scholar] [CrossRef] [PubMed]
- Hamy, A.-S.; Pierga, J.-Y.; Sabaila, A.; Laas, E.; Bonsang-Kitzis, H.; Laurent, C.; Vincent-Salomon, A.; Cottu, P.; Lerebours, F.; Rouzier, R.; et al. Stromal Lymphocyte Infiltration after Neoadjuvant Chemotherapy Is Associated with Aggressive Residual Disease and Lower Disease-Free Survival in HER2-Positive Breast Cancer. Ann. Oncol. 2017, 28, 2233–2240. [Google Scholar] [CrossRef]
- Salgado, R.; Denkert, C.; Campbell, C.; Savas, P.; Nuciforo, P.; Nucifero, P.; Aura, C.; de Azambuja, E.; Eidtmann, H.; Ellis, C.E.; et al. Tumor-Infiltrating Lymphocytes and Associations With Pathological Complete Response and Event-Free Survival in HER2-Positive Early-Stage Breast Cancer Treated With Lapatinib and Trastuzumab: A Secondary Analysis of the NeoALTTO Trial. JAMA Oncol. 2015, 1, 448–455. [Google Scholar] [CrossRef] [PubMed]
- Hwang, C.; Lee, S.J.; Lee, J.H.; Kim, K.H.; Suh, D.S.; Kwon, B.-S.; Choi, K.U. Stromal Tumor-Infiltrating Lymphocytes Evaluated on H&E-Stained Slides Are an Independent Prognostic Factor in Epithelial Ovarian Cancer and Ovarian Serous Carcinoma. Oncol. Lett. 2019, 17, 4557–4565. [Google Scholar] [CrossRef] [PubMed]
- Barnes, T.A.; Amir, E. HYPE or HOPE: The Prognostic Value of Infiltrating Immune Cells in Cancer. Br. J. Cancer 2017, 117, 451–460. [Google Scholar] [CrossRef] [PubMed]
- Cerbelli, B.; Scagnoli, S.; Mezi, S.; Luca, A.D.; Pisegna, S.; Amabile, M.I.; Roberto, M.; Fortunato, L.; Costarelli, L.; Pernazza, A.; et al. Tissue Immune Profile: A Tool to Predict Response to Neoadjuvant Therapy in Triple Negative Breast Cancer. Cancers 2020, 12, 2648. [Google Scholar] [CrossRef] [PubMed]
- Ahn, S.G.; Cha, Y.J.; Bae, S.J.; Yoon, C.; Lee, H.W.; Jeong, J. Comparisons of Tumor-Infiltrating Lymphocyte Levels and the 21-Gene Recurrence Score in ER-Positive/HER2-Negative Breast Cancer. BMC Cancer 2018, 18, 320. [Google Scholar] [CrossRef]
- Laenkholm, A.-V.; Callagy, G.; Balancin, M.; Bartlett, J.M.S.; Sotiriou, C.; Marchio, C.; Kok, M.; Anjos, C.H.D.; Salgado, R. Incorporation of TILs in Daily Breast Cancer Care: How Much Evidence Can We Bear? Virchows Arch. 2022, 480, 147–162. [Google Scholar] [CrossRef]
- Maibach, F.; Sadozai, H.; Jafari, S.M.S.; Hunger, R.E.; Schenk, M. Tumor-Infiltrating Lymphocytes and Their Prognostic Value in Cutaneous Melanoma. Front. Immunol. 2020, 11, 2105. [Google Scholar] [CrossRef]
- Azimi, F.; Scolyer, R.A.; Rumcheva, P.; Moncrieff, M.; Murali, R.; McCarthy, S.W.; Saw, R.P.; Thompson, J.F. Tumor-Infiltrating Lymphocyte Grade Is an Independent Predictor of Sentinel Lymph Node Status and Survival in Patients with Cutaneous Melanoma. J. Clin. Oncol. 2012, 30, 2678–2683. [Google Scholar] [CrossRef]
- Loi, S.; Adams, S.; Schmid, P.; Cortés, J.; Cescon, D.W.; Winer, E.P.; Toppmeyer, D.L.; Rugo, H.S.; Laurentiis, M.D.; Nanda, R.; et al. Relationship between Tumor Infiltrating Lymphocyte (TIL) Levels and Response to Pembrolizumab (Pembro) in Metastatic Triple-Negative Breast Cancer (MTNBC): Results from KEYNOTE-086. Ann. Oncol. 2017, 28, v608. [Google Scholar] [CrossRef]
- Balatoni, T.; Mohos, A.; Papp, E.; Sebestyén, T.; Liszkay, G.; Oláh, J.; Varga, A.; Lengyel, Z.; Emri, G.; Gaudi, I.; et al. Tumor-Infiltrating Immune Cells as Potential Biomarkers Predicting Response to Treatment and Survival in Patients with Metastatic Melanoma Receiving Ipilimumab Therapy. Cancer Immunol. Immunother. 2018, 67, 141–151. [Google Scholar] [CrossRef]
- Tumeh, P.C.; Harview, C.L.; Yearley, J.H.; Shintaku, I.P.; Taylor, E.J.M.; Robert, L.; Chmielowski, B.; Spasic, M.; Henry, G.; Ciobanu, V.; et al. PD-1 Blockade Induces Responses by Inhibiting Adaptive Immune Resistance. Nature 2014, 515, 568–571. [Google Scholar] [CrossRef]
- Dieu-Nosjean, M.-C.; Goc, J.; Giraldo, N.A.; Sautès-Fridman, C.; Fridman, W.H. Tertiary Lymphoid Structures in Cancer and Beyond. Trends Immunol. 2014, 35, 571–580. [Google Scholar] [CrossRef]
- Silina, K.; Soltermann, A.; Attar, F.M.; Casanova, R.; Uckeley, Z.M.; Thut, H.; Wandres, M.; Isajevs, S.; Cheng, P.F.; Fontecedro, A.C.; et al. Germinal Centers Determine the Prognostic Relevance of Tertiary Lymphoid Structures and Are Impaired by Corticosteroids in Lung Squamous Cell Carcinoma. Cancer Res. 2017, 78, 1308–1320. [Google Scholar] [CrossRef] [PubMed]
- Posch, F.; Silina, K.; Leibl, S.; Mündlein, A.; Moch, H.; Siebenhüner, A.; Samaras, P.; Riedl, J.; Stotz, M.; Szkandera, J.; et al. Maturation of Tertiary Lymphoid Structures and Recurrence of Stage II and III Colorectal Cancer. Oncoimmunology 2017, 7, e1378844. [Google Scholar] [CrossRef] [PubMed]
- Barber, M.R.; Yang, T.J. Tumor Infiltrating Lymphocytes: CD8+ Lymphocytes in Canine Transmissible Venereal Sarcomas at Different Stages of Tumor Growth. Anticancer. Res. 1999, 19, 1137–1142. [Google Scholar]
- Trail, P.A.; Yang, T.J. Canine Transmissible Venereal Sarcoma: Quantitation of T-Lymphocyte Subpopulations during Progressive Growth and Spontaneous Tumor Regression. J. Natl. Cancer Inst. 1985, 74, 461–467. [Google Scholar]
- Hsiao, Y.-W.; Liao, K.-W.; Hung, S.-W.; Chu, R.-M. Effect of Tumor Infiltrating Lymphocytes on the Expression of MHC Molecules in Canine Transmissible Venereal Tumor Cells. Vet. Immunol. Immunopathol. 2002, 87, 19–27. [Google Scholar] [CrossRef]
- Kim, J.-H.; Yu, C.-H.; Yhee, J.-Y.; Im, K.-S.; Sur, J.-H. Lymphocyte Infiltration, Expression of Interleukin (IL) -1, IL-6 and Expression of Mutated Breast Cancer Susceptibility Gene-1 Correlate with Malignancy of Canine Mammary Tumours. J. Comp. Pathol. 2010, 142, 177–186. [Google Scholar] [CrossRef] [PubMed]
- Kim, J.-H.; Chon, S.-K.; Im, K.-S.; Kim, N.-H.; Sur, J.-H. Correlation of Tumor-Infiltrating Lymphocytes to Histopathological Features and Molecular Phenotypes in Canine Mammary Carcinoma: A Morphologic and Immunohistochemical Morphometric Study. Can. J. Vet. Res. 2011, 77, 142–149. [Google Scholar]
- Gameiro, A.; Nascimento, C.; Correia, J.; Ferreira, F. VISTA Is a Diagnostic Biomarker and Immunotherapy Target of Aggressive Feline Mammary Carcinoma Subtypes. Cancers 2021, 13, 5559. [Google Scholar] [CrossRef]
- Estrela-Lima, A.; Araújo, M.S.; Costa-Neto, J.M.; Teixeira-Carvalho, A.; Barrouin-Melo, S.M.; Cardoso, S.V.; Martins-Filho, O.A.; Serakides, R.; Cassali, G.D. Immunophenotypic Features of Tumor Infiltrating Lymphocytes from Mammary Carcinomas in Female Dogs Associated with Prognostic Factors and Survival Rates. BMC Cancer 2010, 10, 256. [Google Scholar] [CrossRef]
- Carvalho, M.I.; Pires, I.; Prada, J.; Queiroga, F.L. T-Lymphocytic Infiltrate in Canine Mammary Tumours: Clinic and Prognostic Implications. In Vivo 2011, 25, 963–969. [Google Scholar]
- Muscatello, L.V.; Avallone, G.; Brunetti, B.; Bacci, B.; Foschini, M.P.; Sarli, G. Standardized Approach for Evaluating Tumor Infiltrating Lymphocytes in Canine Mammary Carcinoma: Spatial Distribution and Score as Relevant Features of Tumor Malignancy. Vet. J. 2022, 283–284, 105833. [Google Scholar] [CrossRef] [PubMed]
- Tominaga, M.; Horiuchi, Y.; Ichikawa, M.; Yamashita, M.; Okano, K.; Jikumaru, Y.; Nariai, Y.; Kadosawa, T. Flow Cytometric Analysis of Peripheral Blood and Tumor-Infiltrating Regulatory T Cells in Dogs with Oral Malignant Melanoma. J. Vet. Diagn. Investig. 2010, 22, 438–441. [Google Scholar] [CrossRef] [PubMed][Green Version]
- Porcellato, I.; Silvestri, S.; Menchetti, L.; Recupero, F.; Mechelli, L.; Sforna, M.; Iussich, S.; Bongiovanni, L.; Lepri, E.; Brachelente, C. Tumour-infiltrating Lymphocytes in Canine Melanocytic Tumours: An Investigation on the Prognostic Role of CD3+ and CD20+ Lymphocytic Populations. Vet. Comp. Oncol. 2020, 18, 370–380. [Google Scholar] [CrossRef]
- Yasumaru, C.C.; Xavier, J.G.; Strefezzi, R.D.F.; Salles-Gomes, C.O.M. Intratumoral T-Lymphocyte Subsets in Canine Oral Melanoma and Their Association With Clinical and Histopathological Parameters. Vet. Pathol. 2021, 58, 491–502. [Google Scholar] [CrossRef] [PubMed]
- Stevenson, V.B.; Perry, S.N.; Todd, M.; Huckle, W.R.; LeRoith, T. PD-1, PD-L1, and PD-L2 Gene Expression and Tumor Infiltrating Lymphocytes in Canine Melanoma. Vet. Pathol. 2021, 58, 692–698. [Google Scholar] [CrossRef] [PubMed]
- Withers, S.S.; York, D.; Choi, J.W.; Woolard, K.D.; Laufer-Amorim, R.; Sparger, E.E.; Burton, J.H.; McSorley, S.J.; Monjazeb, A.M.; Murphy, W.J.; et al. Metastatic Immune Infiltrates Correlate with Those of the Primary Tumour in Canine Osteosarcoma. Vet. Comp. Oncol. 2019, 17, 242–252. [Google Scholar] [CrossRef] [PubMed]
- Sorenson, L.; Fu, Y.; Hood, T.; Warren, S.; McEachron, T.A. Targeted Transcriptional Profiling of the Tumor Microenvironment Reveals Lymphocyte Exclusion and Vascular Dysfunction in Metastatic Osteosarcoma. Oncoimmunology 2019, 8, e1629779. [Google Scholar] [CrossRef]
- Regan, D.P.; Chow, L.; Das, S.; Haines, L.; Palmer, E.; Kurihara, J.; Coy, J.; Mathias, A.; Thamm, D.H.; Gustafson, D.L.; et al. Losartan Blocks Osteosarcoma-Elicited Monocyte Recruitment, and Combined with the Kinase Inhibitor Toceranib, Exerts Significant Clinical Benefit in Canine Metastatic Osteosarcoma. Clin. Cancer Res. 2021, 28, 662–676. [Google Scholar] [CrossRef]
- Biller, B.J.; Guth, A.; Burton, J.H.; Dow, S.W. Decreased Ratio of CD8+ T Cells to Regulatory T Cells Associated with Decreased Survival in Dogs with Osteosarcoma. J. Vet. Intern. Med. 2010, 24, 1118–1123. [Google Scholar] [CrossRef]
- Cascio, M.J.; Whitley, E.M.; Sahay, B.; Cortes-Hinojosa, G.; Chang, L.-J.; Cowart, J.; Salute, M.; Sayour, E.; Dark, M.; Sandoval, Z.; et al. Canine Osteosarcoma Checkpoint Expression Correlates with Metastasis and T-Cell Infiltrate. Vet. Immunol. Immunopathol 2021, 232, 110169. [Google Scholar] [CrossRef]
- Moore, P.F. A Review of Histiocytic Diseases of Dogs and Cats. Vet. Pathol. 2014, 51, 167–184. [Google Scholar] [CrossRef] [PubMed]
- Kaim, U.; Moritz, A.; Failing, K.; Baumgärtner, W. The Regression of a Canine Langerhans Cell Tumour Is Associated with Increased Expression of IL-2, TNF-α, IFN-γ and INOS MRNA. Immunology 2006, 118, 472–482. [Google Scholar] [CrossRef]
- Pires, I.; Rodrigues, P.; Alves, A.; Queiroga, F.L.; Silva, F.; Lopes, C. Immunohistochemical and Immunoelectron Study of Major Histocompatibility Complex Class-II Antigen in Canine Cutaneous Histiocytoma: Its Relation to Tumor Regression. In Vivo 2013, 27, 257–262. [Google Scholar] [PubMed]
- Lenz, J.A.; Assenmacher, C.-A.; Costa, V.; Louka, K.; Rau, S.; Keuler, N.S.; Zhang, P.J.; Maki, R.G.; Durham, A.C.; Radaelli, E.; et al. Increased Tumor-Infiltrating Lymphocyte Density Is Associated with Favorable Outcomes in a Comparative Study of Canine Histiocytic Sarcoma. Cancer Immunol. Immunother. 2021, 71, 807–818. [Google Scholar] [CrossRef] [PubMed]
- Castro, D.P.; José-López, R.; Flores, F.F.; Prados, R.M.R.; Mandara, M.T.; Arús, C.; Batlle, M.P. Expression of FOXP3 in Canine Gliomas: Immunohistochemical Study of Tumor-Infiltrating Regulatory Lymphocytes. J. Neuropathol. Exp. Neurol. 2019, 79, 184–193. [Google Scholar] [CrossRef] [PubMed]
- Krane, G.A.; O’Dea, C.A.; Malarkey, D.E.; Miller, A.D.; Miller, C.R.; Tokarz, D.A.; Jensen, H.L.; Janardhan, K.S.; Shockley, K.R.; Flagler, N.; et al. Immunohistochemical Evaluation of Immune Cell Infiltration in Canine Gliomas. Vet. Pathol. 2021, 58, 952–963. [Google Scholar] [CrossRef]
- Palmieri, C.; Hood, G.; Fonseca-Alves, C.E.; Laufer-Amorim, R.; Allavena, R. An Immunohistochemical Study of T and B Lymphocyte Density in Prostatic Hyperplasia and Prostate Carcinoma in Dogs. Res. Vet. Sci. 2018, 122, 189–192. [Google Scholar] [CrossRef]
- Maeda, S.; Motegi, T.; Iio, A.; Kaji, K.; Goto-Koshino, Y.; Eto, S.; Ikeda, N.; Nakagawa, T.; Nishimura, R.; Yonezawa, T.; et al. Anti-CCR4 Treatment Depletes Regulatory T Cells and Leads to Clinical Activity in a Canine Model of Advanced Prostate Cancer. J. Immunother. Cancer 2022, 10, e003731. [Google Scholar] [CrossRef]
- Inoue, A.; Maeda, S.; Kinoshita, R.; Tsuboi, M.; Yonezawa, T.; Matsuki, N. Density of Tumor-Infiltrating Granzyme B-Positive Cells Predicts Favorable Prognosis in Dogs with Transitional Cell Carcinoma. Vet. Immunol. Immunopathol. 2017, 190, 53–56. [Google Scholar] [CrossRef]
- Sakai, K.; Maeda, S.; Yamada, Y.; Chambers, J.K.; Uchida, K.; Nakayama, H.; Yonezawa, T.; Matsuki, N. Association of Tumour-infiltrating Regulatory T Cells with Adverse Outcomes in Dogs with Malignant Tumours. Vet. Comp. Oncol. 2018, 16, 330–336. [Google Scholar] [CrossRef]
- Varallo, G.R.; Gelaleti, G.B.; Maschio-Signorini, L.B.; Moschetta, M.G.; Lopes, J.R.; Nardi, A.B.D.; Tinucci-Costa, M.; Rocha, R.M.; Zuccari, D.A.P.D.C. Prognostic Phenotypic Classification for Canine Mammary Tumors. Oncol. Lett. 2019, 18, 6545–6553. [Google Scholar] [CrossRef] [PubMed]
- Sorenmo, K.U.; Kristiansen, V.M.; Cofone, M.A.; Shofer, F.S.; Breen, A.-M.; Langeland, M.; Mongil, C.M.; Grondahl, A.M.; Teige, J.; Goldschmidt, M.H. Canine Mammary Gland Tumours; a Histological Continuum from Benign to Malignant; Clinical and Histopathological Evidence. Vet. Comp. Oncol. 2009, 7, 162–172. [Google Scholar] [CrossRef] [PubMed]
- Beha, G.; Brunetti, B.; Asproni, P.; Muscatello, L.V.; Millanta, F.; Poli, A.; Sarli, G.; Benazzi, C. Molecular Portrait-Based Correlation between Primary Canine Mammary Tumor and Its Lymph Node Metastasis: Possible Prognostic-Predictive Models and/or Stronghold for Specific Treatments? BMC Vet. Res. 2012, 8, 219. [Google Scholar] [CrossRef] [PubMed]
- Thumser-Henner, P.; Nytko, K.J.; Bley, C.R. Mutations of BRCA2 in Canine Mammary Tumors and Their Targeting Potential in Clinical Therapy. BMC Vet. Res. 2020, 16, 30. [Google Scholar] [CrossRef]
- Pastor, N.; Ezquerra, L.J.; Santella, M.; Caballé, N.C.; Tarazona, R.; Durán, M.E. Prognostic Significance of Immunohistochemical Markers and Histological Classification in Malignant Canine Mammary Tumours. Vet. Comp. Oncol. 2020, 18, 753–762. [Google Scholar] [CrossRef]
- Nguyen, F.; Peña, L.; Ibisch, C.; Loussouarn, D.; Gama, A.; Rieder, N.; Belousov, A.; Campone, M.; Abadie, J. Canine Invasive Mammary Carcinomas as Models of Human Breast Cancer Part 1: Natural History and Prognostic Factors. Breast Cancer Res. Treat. 2018, 167, 635–648. [Google Scholar] [CrossRef]
- Abadie, J.; Nguyen, F.; Loussouarn, D.; Peña, L.; Gama, A.; Rieder, N.; Belousov, A.; Bemelmans, I.; Jaillardon, L.; Ibisch, C.; et al. Canine Invasive Mammary Carcinomas as Models of Human Breast Cancer. Part 2: Immunophenotypes and Prognostic Significance. Breast Cancer Res. Treat. 2018, 167, 459–468. [Google Scholar] [CrossRef]
- Saba, C.; Paoloni, M.; Mazcko, C.; Kisseberth, W.; Burton, J.H.; Smith, A.; Wilson-Robles, H.; Allstadt, S.; Vail, D.; Henry, C.; et al. A Comparative Oncology Study of Iniparib Defines Its Pharmacokinetic Profile and Biological Activity in a Naturally-Occurring Canine Cancer. Model. PLoS ONE 2016, 11, e0149194. [Google Scholar] [CrossRef]
- Soria, G.; Ben-Baruch, A. The Inflammatory Chemokines CCL2 and CCL5 in Breast Cancer. Cancer Lett. 2008, 267, 271–285. [Google Scholar] [CrossRef]
- van der Weyden, L.; Brenn, T.; Patton, E.E.; Wood, G.A.; Adams, D.J. Spontaneously Occurring Melanoma in Animals and Their Relevance to Human Melanoma. J. Pathol. 2020, 252, 4–21. [Google Scholar] [CrossRef]
- van der Wong, K.; Weyden, L.; Schott, C.R.; Foote, A.; Constantino-Casas, F.; Smith, S.; Dobson, J.M.; Murchison, E.P.; Wu, H.; Yeh, I.; et al. Cross-Species Genomic Landscape Comparison of Human Mucosal Melanoma with Canine Oral and Equine Melanoma. Nat. Commun. 2019, 10, 353. [Google Scholar] [CrossRef] [PubMed]
- Blacklock, K.L.B.; Birand, Z.; Selmic, L.E.; Nelissen, P.; Murphy, S.; Blackwood, L.; Bass, J.; McKay, J.; Fox, R.; Beaver, S.; et al. Genome-Wide Analysis of Canine Oral Malignant Melanoma Metastasis-Associated Gene Expression. Sci. Rep. 2019, 9, 6511. [Google Scholar] [CrossRef] [PubMed]
- Rahman, M.M.; Lai, Y.-C.; Husna, A.A.; Chen, H.-W.; Tanaka, Y.; Kawaguchi, H.; Hatai, H.; Miyoshi, N.; Nakagawa, T.; Fukushima, R.; et al. Transcriptome Analysis of Dog Oral Melanoma and Its Oncogenic Analogy with Human Melanoma. Oncol. Rep. 2020, 43, 16–30. [Google Scholar] [CrossRef]
- Maekawa, N.; Konnai, S.; Okagawa, T.; Nishimori, A.; Ikebuchi, R.; Izumi, Y.; Takagi, S.; Kagawa, Y.; Nakajima, C.; Suzuki, Y.; et al. Immunohistochemical Analysis of PD-L1 Expression in Canine Malignant Cancers and PD-1 Expression on Lymphocytes in Canine Oral Melanoma. PLoS ONE 2016, 11, e0157176. [Google Scholar] [CrossRef] [PubMed]
- Grosenbaugh, D.A.; Leard, A.T.; Bergman, P.J.; Klein, M.K.; Meleo, K.; Susaneck, S.; Hess, P.R.; Jankowski, M.K.; Jones, P.D.; Leibman, N.F.; et al. Safety and Efficacy of a Xenogeneic DNA Vaccine Encoding for Human Tyrosinase as Adjunctive Treatment for Oral Malignant Melanoma in Dogs Following Surgical Excision of the Primary Tumor. Am. J. Vet. Res. 2011, 72, 1631–1638. [Google Scholar] [CrossRef] [PubMed]
- Gardner, H.L.; Sivaprakasam, K.; Briones, N.; Zismann, V.; Perdigones, N.; Drenner, K.; Facista, S.; Richholt, R.; Liang, W.; Aldrich, J.; et al. Canine Osteosarcoma Genome Sequencing Identifies Recurrent Mutations in DMD and the Histone Methyltransferase Gene SETD2. Commun. Biol. 2019, 2, 266. [Google Scholar] [CrossRef] [PubMed]
- Shao, Y.W.; Wood, G.A.; Lu, J.; Tang, Q.-L.; Liu, J.; Molyneux, S.; Chen, Y.; Fang, H.; Adissu, H.; McKee, T.; et al. Cross-Species Genomics Identifies DLG2 as a Tumor Suppressor in Osteosarcoma. Oncogene 2019, 38, 291–298. [Google Scholar] [CrossRef] [PubMed]
- Fowles, J.S.; Brown, K.C.; Hess, A.M.; Duval, D.L.; Gustafson, D.L. Intra- and Interspecies Gene Expression Models for Predicting Drug Response in Canine Osteosarcoma. BMC Bioinform. 2016, 17, 93. [Google Scholar] [CrossRef] [PubMed]
- Luo, Z.-W.; Liu, P.-P.; Wang, Z.-X.; Chen, C.-Y.; Xie, H. Macrophages in Osteosarcoma Immune Microenvironment: Implications for Immunotherapy. Front. Oncol. 2020, 10, 586580. [Google Scholar] [CrossRef]
- Fritzsching, B.; Fellenberg, J.; Moskovszky, L.; Sápi, Z.; Krenacs, T.; Machado, I.; Poeschl, J.; Lehner, B.; Szendrõi, M.; Bosch, A.L.; et al. CD8+/FOXP3+-Ratio in Osteosarcoma Microenvironment Separates Survivors from Non-Survivors: A Multicenter Validated Retrospective Study. Oncoimmunology 2015, 4, e990800. [Google Scholar] [CrossRef]
- Affolter, V.K.; Moore, P.F. Localized and Disseminated Histiocytic Sarcoma of Dendritic Cell Origin in Dogs. Vet. Pathol. Online 2002, 39, 74–83. [Google Scholar] [CrossRef]
- Abadie, J.; Hédan, B.; Cadieu, E.; Brito, C.D.; Devauchelle, P.; Bourgain, C.; Parker, H.G.; Vaysse, A.; Margaritte-Jeannin, P.; Galibert, F.; et al. Epidemiology, Pathology, and Genetics of Histiocytic Sarcoma in the Bernese Mountain Dog Breed. J. Hered. 2009, 100, S19–S27. [Google Scholar] [CrossRef]
- Fidel, J.; Schiller, I.; Hauser, B.; Jausi, Y.; Rohrer-Bley, C.; Roos, M.; Kaser-Hotz, B. Histiocytic Sarcomas in Flat-coated Retrievers: A Summary of 37 Cases (November 1998–March 2005). Vet. Comp. Oncol. 2006, 4, 63–74. [Google Scholar] [CrossRef] [PubMed]
- Hedan, B.; Thomas, R.; Motsinger-Reif, A.; Abadie, J.; Andre, C.; Cullen, J.; Breen, M. Molecular Cytogenetic Characterization of Canine Histiocytic Sarcoma: A Spontaneous Model for Human Histiocytic Cancer Identifies Deletion of Tumor Suppressor Genes and Highlights Influence of Genetic Background on Tumor Behavior. BMC Cancer 2011, 11, 201. [Google Scholar] [CrossRef] [PubMed]
- Purzycka, K.; Peters, L.M.; Elliott, J.; Lamb, C.R.; Priestnall, S.L.; Hardas, A.; Johnston, C.A.; Rodriguez-Piza, I. Histiocytic Sarcoma in Miniature Schnauzers: 30 Cases. J. Small Anim. Pract. 2020, 61, 338–345. [Google Scholar] [CrossRef]
- Lenz, J.A.; Furrow, E.; Craig, L.E.; Cannon, C.M. Histiocytic Sarcoma in 14 Miniature Schnauzers—A New Breed Predisposition? J. Small Anim. Pract. 2017, 58, 461–467. [Google Scholar] [CrossRef]
- Takada, M.; Hix, J.M.L.; Corner, S.; Schall, P.Z.; Kiupel, M.; Yuzbasiyan-Gurkan, V. Targeting MEK in a Translational Model of Histiocytic Sarcoma. Mol. Cancer Ther. 2018, 17, 2439–2450. [Google Scholar] [CrossRef] [PubMed]
- Moore, P.F.; Schrenzel, M.D.; Affolter, V.K.; Olivry, T.; Naydan, D. Canine Cutaneous Histiocytoma Is an Epidermotropic Langerhans Cell Histiocytosis That Expresses CD1 and Specific Beta 2-Integrin Molecules. Am. J. Pathol. 1996, 148, 1699–1708. [Google Scholar] [PubMed]
- Marcinowska, A.; Constantino-Casas, F.; Williams, T.; Hoather, T.; Blacklaws, B.; Dobson, J. T Lymphocytes in Histiocytic Sarcomas of Flat-Coated Retriever Dogs. Vet. Pathol. 2017, 54, 605–610. [Google Scholar] [CrossRef]
- Hicks, J.; Platt, S.; Kent, M.; Haley, A. Canine Brain Tumours: A Model for the Human Disease? Vet. Comp. Oncol. 2015, 15, 252–272. [Google Scholar] [CrossRef]
- Mutsaers, A.J.; Widmer, W.R.; Knapp, D.W. Canine Transitional Cell Carcinoma. J. Vet. Intern. Med. 2003, 17, 136–144. [Google Scholar] [CrossRef] [PubMed]
- Rossman, P.; Zabka, T.S.; Ruple, A.; Tuerck, D.; Ramos-Vara, J.A.; Liu, L.; Mohallem, R.; Merchant, M.; Franco, J.; Fulkerson, C.M.; et al. Phase I/II Trial of Vemurafenib in Dogs with Naturally-Occurring, BRAF-Mutated Urothelial Carcinoma. Mol. Cancer Ther. 2021, 20, 2177–2188. [Google Scholar] [CrossRef] [PubMed]
- Decker, B.; Parker, H.G.; Dhawan, D.; Kwon, E.M.; Karlins, E.; Davis, B.W.; Ramos-Vara, J.A.; Bonney, P.L.; McNiel, E.A.; Knapp, D.W.; et al. Homologous Mutation to Human BRAF V600E Is Common in Naturally Occurring Canine Bladder Cancer—Evidence for a Relevant Model System and Urine-Based Diagnostic Test. Mol. Cancer Res. 2015, 13, 993–1002. [Google Scholar] [CrossRef]
- Gambim, V.V.; Laufer-Amorim, R.; Alves, R.H.F.; Grieco, V.; Fonseca-Alves, C.E. A Comparative Meta-Analysis and in Silico Analysis of Differentially Expressed Genes and Proteins in Canine and Human Bladder Cancer. Front. Vet. Sci. 2020, 7, 558978. [Google Scholar] [CrossRef]
- Mochizuki, H.; Breen, M. Comparative Aspects of BRAF Mutations in Canine Cancers. Vet. Sci. 2015, 2, 231–245. [Google Scholar] [CrossRef]
- Mochizuki, H.; Shapiro, S.G.; Breen, M. Detection of BRAF Mutation in Urine DNA as a Molecular Diagnostic for Canine Urothelial and Prostatic Carcinoma. PLoS ONE 2015, 10, e0144170. [Google Scholar] [CrossRef]
- Pinard, C.J.; Hocker, S.E.; Poon, A.C.; Inkol, J.M.; Matsuyama, A.; Wood, R.D.; Wood, G.A.; Woods, J.P.; Mutsaers, A.J. Evaluation of PD-1 and PD-L1 Expression in Canine Urothelial Carcinoma Cell Lines. Vet. Immunol. Immunopathol. 2021, 243, 110367. [Google Scholar] [CrossRef]
- Sommer, B.C.; Dhawan, D.; Ruple, A.; Ramos-Vara, J.A.; Hahn, N.M.; Utturkar, S.M.; Ostrander, E.A.; Parker, H.G.; Fulkerson, C.M.; Childress, M.O.; et al. Basal and Luminal Molecular Subtypes in Naturally-Occurring Canine Urothelial Carcinoma Are Associated with Tumor Immune Signatures and Dog Breed. Bladder Cancer 2021, 7, 317–333. [Google Scholar] [CrossRef]
- Chand, D.; Dhawan, D.; Sankin, A.; Ren, X.; Lin, J.; Schoenberg, M.; Knapp, D.W.; Zang, X. Immune Checkpoint B7x (B7-H4/B7S1/VTCN1) Is Over Expressed in Spontaneous Canine Bladder Cancer: The First Report and Its Implications in a Preclinical Model. Bladder Cancer 2019, 5, 63–71. [Google Scholar] [CrossRef]
- Strasner, A.; Karin, M. Immune Infiltration and Prostate Cancer. Front. Oncol. 2015, 5, 128. [Google Scholar] [CrossRef]
- Lorch, G.; Sivaprakasam, K.; Zismann, V.; Perdigones, N.; Contente-Cuomo, T.; Nazareno, A.; Facista, S.; Wong, S.; Drenner, K.; Liang, W.S.; et al. Identification of Recurrent Activating HER2 Mutations in Primary Canine Pulmonary Adenocarcinoma. Clin. Cancer Res. 2019, 25, 5866–5877. [Google Scholar] [CrossRef]
- Griffey, S.M.; Kraegel, S.A.; Madewell, B.R. Rapid Detection of K-Ras Gene Mutations in Canine Lung Cancer Using Single-Strand Conformational Polymorphism Analysis. Carcinogenesis 1998, 19, 959–963. [Google Scholar] [CrossRef]
- Shintani, Y.; Fujiwara, A.; Kimura, T.; Kawamura, T.; Funaki, S.; Minami, M.; Okumura, M. IL-6 Secreted from Cancer-Associated Fibroblasts Mediates Chemoresistance in NSCLC by Increasing Epithelial-Mesenchymal Transition Signaling. J. Thorac. Oncol. 2016, 11, 1482–1492. [Google Scholar] [CrossRef]
- Chang, C.H.; Hsiao, C.F.; Yeh, Y.M.; Chang, G.C.; Tsai, Y.H.; Chen, Y.M.; Huang, M.S.; Chen, H.L.; Li, Y.J.; Yang, P.C.; et al. Circulating Interleukin-6 Level Is a Prognostic Marker for Survival in Advanced Nonsmall Cell Lung Cancer Patients Treated with Chemotherapy. Int. J. Cancer 2013, 132, 1977–1985. [Google Scholar] [CrossRef]
- Johnson, D.E.; O’Keefe, R.A.; Grandis, J.R. Targeting the IL-6/JAK/STAT3 Signalling Axis in Cancer. Nat. Rev. Clin. Oncol. 2018, 15, 234–248. [Google Scholar] [CrossRef]
- Stathopoulos, G.P.; Armakolas, A.; Tranga, T.; Marinou, H.; Stathopoulos, J.; Chandrinou, H. Granulocyte Colony-Stimulating Factor Expression as a Prognostic Biomarker in Non-Small Cell Lung Cancer. Oncol. Rep. 2011, 25, 1541–1544. [Google Scholar] [CrossRef][Green Version]
- Bujak, J.K.; Szopa, I.M.; Pingwara, R.; Kruczyk, O.; Krzemińska, N.; Mucha, J.; Majchrzak-Kuligowska, K. The Expression of Selected Factors Related to T Lymphocyte Activity in Canine Mammary Tumors. Int. J. Mol. Sci. 2020, 21, 2292. [Google Scholar] [CrossRef]
- Zuraw, A.; Aeffner, F. Whole-Slide Imaging, Tissue Image Analysis, and Artificial Intelligence in Veterinary Pathology: An Updated Introduction and Review. Vet. Pathol. 2022, 59, 6–25. [Google Scholar] [CrossRef]
- Salvi, M.; Molinari, F.; Iussich, S.; Muscatello, L.V.; Pazzini, L.; Benali, S.; Banco, B.; Abramo, F.; Maria, R.D.; Aresu, L. Histopathological Classification of Canine Cutaneous Round Cell Tumors Using Deep Learning: A Multi-Center Study. Front. Vet. Sci. 2021, 8, 640944. [Google Scholar] [CrossRef] [PubMed]
- Aubreville, M.; Bertram, C.A.; Donovan, T.A.; Marzahl, C.; Maier, A.; Klopfleisch, R. A Completely Annotated Whole Slide Image Dataset of Canine Breast Cancer to Aid Human Breast Cancer Research. Sci. Data 2020, 7, 417. [Google Scholar] [CrossRef]
- Saltz, J.; Gupta, R.; Hou, L.; Kurc, T.; Singh, P.; Nguyen, V.; Samaras, D.; Shroyer, K.R.; Zhao, T.; Batiste, R.; et al. Spatial Organization and Molecular Correlation of Tumor-Infiltrating Lymphocytes Using Deep Learning on Pathology Images. Cell. Rep. 2018, 23, 181–193.e7. [Google Scholar] [CrossRef]
- Maley, C.C.; Koelble, K.; Natrajan, R.; Aktipis, A.; Yuan, Y. An Ecological Measure of Immune-Cancer Colocalization as a Prognostic Factor for Breast Cancer. Breast Cancer Res. 2015, 17, 131. [Google Scholar] [CrossRef]
- Heindl, A.; Sestak, I.; Naidoo, K.; Cuzick, J.; Dowsett, M.; Yuan, Y. Relevance of Spatial Heterogeneity of Immune Infiltration for Predicting Risk of Recurrence After Endocrine Therapy of ER+ Breast Cancer. J. Natl. Cancer Inst. 2017, 110, 166–175. [Google Scholar] [CrossRef]
- Boddy, A.M.; Harrison, T.M.; Abegglen, L.M. Comparative Oncology: New Insights into an Ancient Disease. Iscience 2020, 23, 101373. [Google Scholar] [CrossRef]

| Tumor Type | Summary of Findings | Reference (s) |
|---|---|---|
| Canine Transmissible Venereal Tumor |
| [103,104] |
| [103,105] | |
| Canine & Feline Mammary Carcinoma |
| [106,107] |
| [106] | |
| [63] | |
| [108] | |
| [109] | |
| [109] | |
| [110] | |
| [111] | |
| Canine Oral Melanoma |
| [112,113] |
| [113] | |
| [113] | |
| [113] | |
| [114] | |
| [115] | |
| Canine Osteosarcoma |
| [43,116,117] |
| [118] | |
| [119] | |
| [120] | |
| Canine Histiocytic Neoplasms |
| [121,122,123] |
| [124] | |
| Canine Glioma |
| [125] |
| [125,126] | |
| Canine Urothelial & Prostate Cancer |
| [127] |
| [127] | |
| [128] | |
| [129] | |
| Canine Pulmonary Carcinoma |
| [130] |
Publisher’s Note: MDPI stays neutral with regard to jurisdictional claims in published maps and institutional affiliations. |
© 2022 by the authors. Licensee MDPI, Basel, Switzerland. This article is an open access article distributed under the terms and conditions of the Creative Commons Attribution (CC BY) license (https://creativecommons.org/licenses/by/4.0/).
Share and Cite
Pinard, C.J., on behalf of the International Immuno-Oncology Biomarker Working Group; Lagree, A.; Lu, F.-I.; Klein, J.; Oblak, M.L.; Salgado, R.; Cardenas, J.C.P.; Brunetti, B.; Muscatello, L.V.; Sarli, G.; et al. Comparative Evaluation of Tumor-Infiltrating Lymphocytes in Companion Animals: Immuno-Oncology as a Relevant Translational Model for Cancer Therapy. Cancers 2022, 14, 5008. https://doi.org/10.3390/cancers14205008
Pinard CJ on behalf of the International Immuno-Oncology Biomarker Working Group, Lagree A, Lu F-I, Klein J, Oblak ML, Salgado R, Cardenas JCP, Brunetti B, Muscatello LV, Sarli G, et al. Comparative Evaluation of Tumor-Infiltrating Lymphocytes in Companion Animals: Immuno-Oncology as a Relevant Translational Model for Cancer Therapy. Cancers. 2022; 14(20):5008. https://doi.org/10.3390/cancers14205008
Chicago/Turabian StylePinard, Christopher J. on behalf of the International Immuno-Oncology Biomarker Working Group, Andrew Lagree, Fang-I Lu, Jonathan Klein, Michelle L. Oblak, Roberto Salgado, Juan Carlos Pinto Cardenas, Barbara Brunetti, Luisa Vera Muscatello, Giuseppe Sarli, and et al. 2022. "Comparative Evaluation of Tumor-Infiltrating Lymphocytes in Companion Animals: Immuno-Oncology as a Relevant Translational Model for Cancer Therapy" Cancers 14, no. 20: 5008. https://doi.org/10.3390/cancers14205008
APA StylePinard, C. J., on behalf of the International Immuno-Oncology Biomarker Working Group, Lagree, A., Lu, F.-I., Klein, J., Oblak, M. L., Salgado, R., Cardenas, J. C. P., Brunetti, B., Muscatello, L. V., Sarli, G., Foschini, M. P., Hardas, A., Castillo, S. P., AbdulJabbar, K., Yuan, Y., Moore, D. A., & Tran, W. T. (2022). Comparative Evaluation of Tumor-Infiltrating Lymphocytes in Companion Animals: Immuno-Oncology as a Relevant Translational Model for Cancer Therapy. Cancers, 14(20), 5008. https://doi.org/10.3390/cancers14205008

